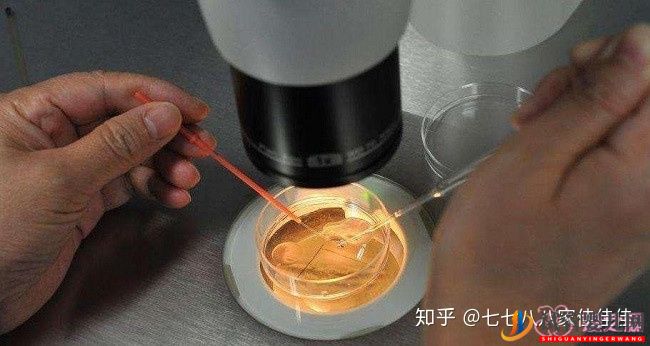

为什么很多明星都选择去美国做试管婴儿
美国试管婴儿或者赴美生子,在纷乱的娱乐圈里屡见不鲜,姚明的女儿在美出生,王宝强的女儿在美国出生,黄渤妻子赴美生二胎,张杰谢娜的双胞胎也被传是在美国做的试管婴儿,为什么那么多明星都选择美国做试管婴儿呢?
美国试管婴儿的第三代美国试管婴儿技术,不仅最大程度提高了不孕不育家庭成功受孕率,在性别选择、丰厚的福利待遇、全球唯一认定第三方合法化和最先进的第三代美国试管婴儿PGS\PGD技术,也保证了宝宝和妈妈的绝对健康,同时也成为赴美生子、赴美合法第三方和不孕不育家庭的首选。
数十年的法律规定,美国至今已经拥有了一套完善的第三方辅助生殖的特殊法律保护条例,在这种特殊的法律保护下,美国试管婴儿生殖医疗中心制定的各种人性化合法条例不仅要求孕妈有生育经验、身体健康,更能全面地保护更多不孕不育患者顺利实现拥有自己健康宝宝的愿望,再无后顾之忧。
性别需求
很多中国人心里还是存在着一点传统的观念,很多人觉得一个孩子成长太孤单,也有人只想要可爱的女儿或者活泼活动的儿子,美国试管PGS/PGD基因筛查技术,可以满足生育者选择男、女宝宝、龙凤胎、双胞胎的愿望。
随着社会经济的发展,很多人都主动或被动地选择推迟生育年龄,随着年龄的增长,卵子的质量也会随之下降,第三代美国试管婴儿合法辅助生殖措施可以帮助多年不孕不育、大龄卵泡数量少、无法自行生育的患者实现好孕梦想。
辅助生育
美国试管婴儿医疗中心有着强大的精卵库和多年严格挑选的第三方辅助生殖中心,可以帮助患者选择合适的孕妈、供卵人、捐精者,全面人性化的法律保护也让很多患者完成愿望。
美国试管婴儿针对无法自行生育或不打算自行生育的女性,更可进行赴美生子计划,运用合法第三方辅助生殖,并通过美国试管婴儿PGS\PGD胚胎筛查诊断技术,在保障宝宝健康的同时,实现生育梦想。

试管门槛
目前,在我国如果需要辅助生殖技术治疗,虽然程序已经简化,但还是需要患者夫妇提供结婚证、身份证,这也就意味着,我国只有合法夫妻才能接受辅助生殖技术的帮助,而单身人士却没有这个机会。但在美国,只要您有需求,无论是夫妻还是单身,都可以借助辅助生殖拥有自己的宝宝。
而且我国目前第三代试管婴儿技术门槛很高,就算是不孕夫妇也需要符合一定条件才能进行第三代试管婴儿技术治疗。





